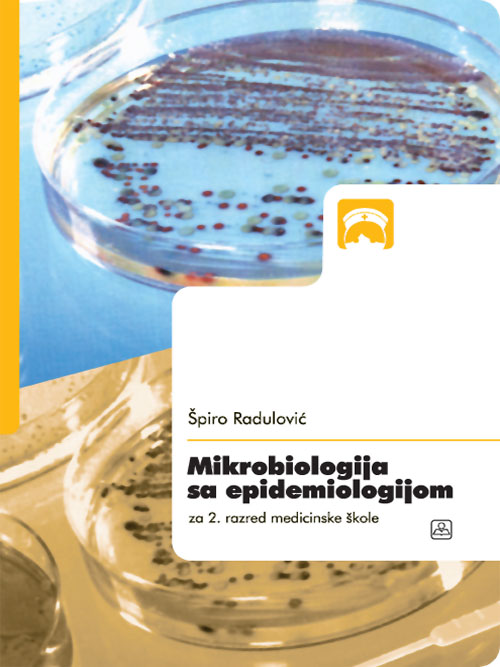

Mikrobiologija sa epidemiologijom za 2. razred medicinske škole
1040 din.

Patologija za 2. razred medicinske škole
960 din.

Anatomija čoveka
0 din.

Аналитичка хемија
1030 din.

Farmaceutska tehnologija 2 za 3. razred medicinske škole
0 din.

Higijena sa zdravstvenim vaspitanjem za 1. ili 2. razred medicinske, prehrambene i srednje škole u delatnosti ličnih usluga
0 din.

Prva pomoć za I razred medicinske škole
1020 din.

Педијатрија са негом 1
605 din.

Farmakologija za 2. razred medcinske škole
970 din.

МЕДИЦИНСКА ЕТИКА за 1. и 2. разред медицинске школе
840 din.

Zbirka rešenih zadataka iz matematike 2 za 2. razred srenjih škola
0 din.

Mikrobiologija sa epidemiologijom: za 2. razred medicinske škole, 14. preštampano izdanje 2017.
1050 din.

Patologija za 2. razred medicinske škole, 14. preštampano izdanje 2017.
960 din.

Zbirka rešenih zadataka iz matematike 3, Veneova zbirka
910 din.

Biologija za 4. razred gimnazije
1040 din.

Budite prvi koji će svoje mišljenje podeliti sa drugima (
Budite prvi koji će svoje mišljenje podeliti sa drugima (